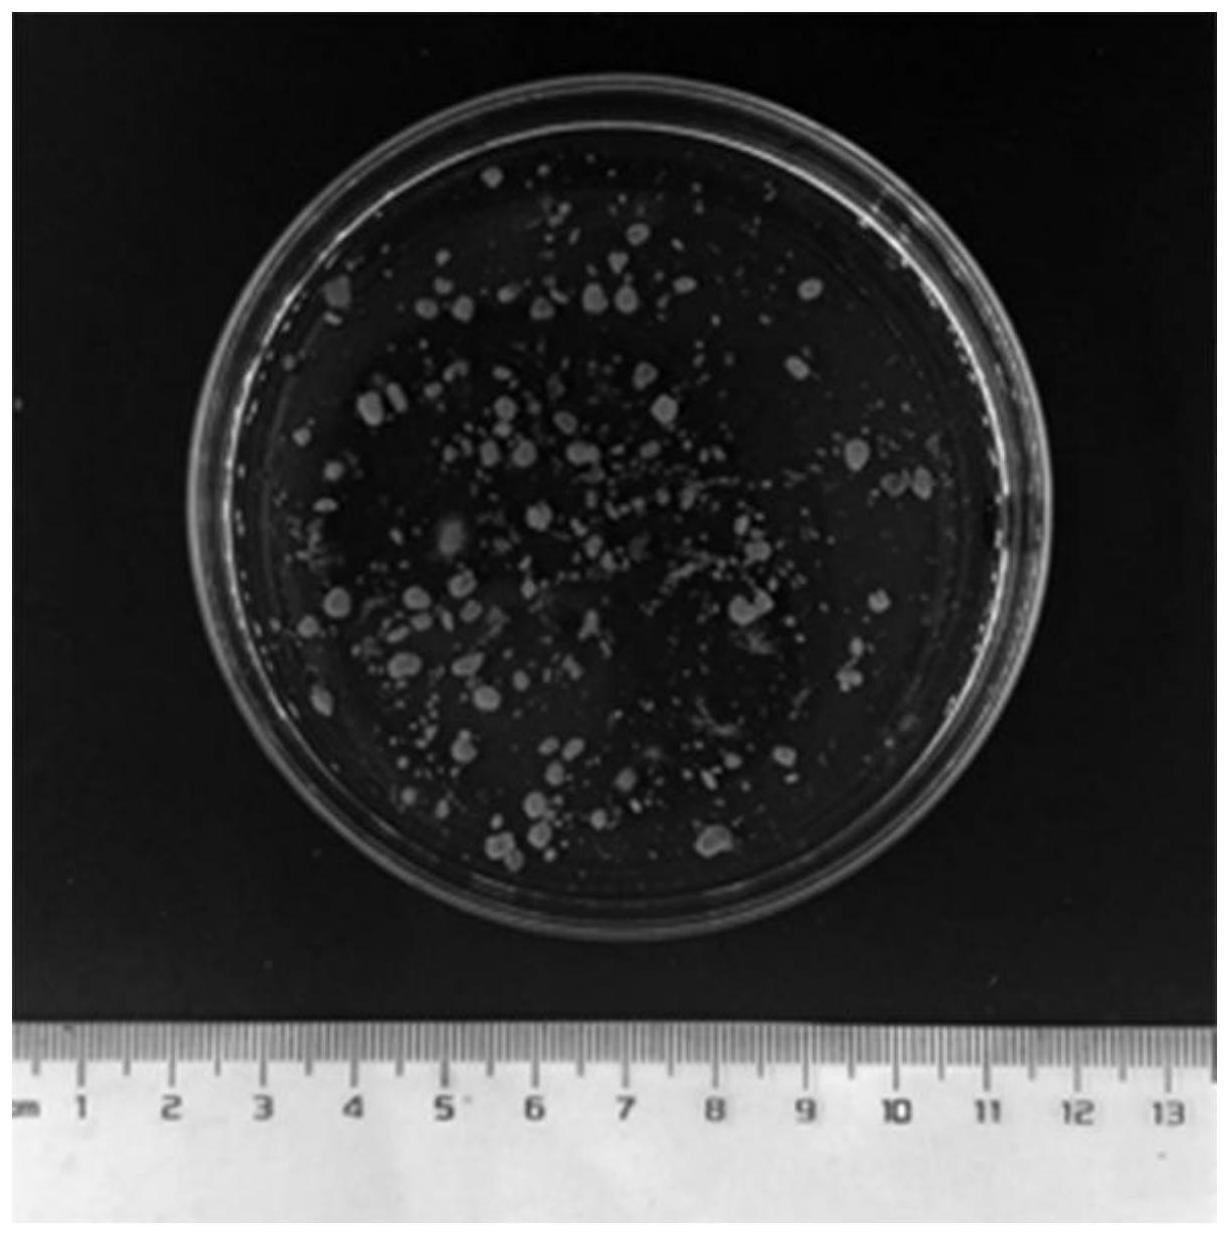
1.jpg

公布日:2023.02.24
申請日:2022.09.20
分類號:C02F3/12(2006.01)I;C02F3/34(2006.01)I;C12N1/14(2006.01)I;C12R1/66(2006.01)N;C12R1/645(2006.01)N;C02F103/10(2006.01)N;C02F101/16(2006.01)N;C02F101/
30(2006.01)N;C02F101/32(2006.01)N;C02F101/38(2006.01)N
摘要
本發(fā)明公開了一種多功能菌絲球強化好氧顆粒污泥處理油氣田壓返液的方法,所述方法包括以下步驟:1)接種真菌菌株,培養(yǎng)成熟后洗滌獲得真菌孢子懸浮液;2)在培養(yǎng)基中接種所述真菌孢子懸浮液,培養(yǎng)并獲得多功能菌絲球;3)在反應器中接種所述多功能菌絲球;4)將廢水引入到反應器中,序批式運行所述反應器處理廢水,培養(yǎng)并獲得所述多功能菌絲球強化型好氧顆粒污泥;其中所述真菌包括聚多曲霉、極細枝孢霉中的至少一種。本發(fā)明可以綠色、經(jīng)濟地實現(xiàn)油氣田壓返液污染物的高效去除。
權利要求書
1.多功能菌絲球強化型好氧顆粒污泥,其特征在于,所述多功能菌絲球強化型好氧顆粒污泥通過包括以下步驟的方法制備得到:1)接種真菌菌株,培養(yǎng)成熟后洗滌獲得真菌孢子懸浮液;2)在培養(yǎng)基中接種所述真菌孢子懸浮液,培養(yǎng)并獲得多功能菌絲球;3)在反應器中接種所述多功能菌絲球;4)將廢水引入到反應器中,序批式運行所述反應器處理廢水,培養(yǎng)并獲得所述多功能菌絲球強化型好氧顆粒污泥;其中所述真菌包括聚多曲霉、極細枝孢霉中的至少一種。
2.根據(jù)權利要求1所述的多功能菌絲球強化型好氧顆粒污泥,其特征在于,所述聚多曲霉的名稱為聚多曲霉NXY1(AspergillussydowiiNXY1),保藏編號為CGMCCNo:40215;所述極細枝孢霉的名稱為極細枝孢霉NXY8(CladosporiumtenuissimumNXY8),保藏編號為CGMCCNo:40141。
3.根據(jù)權利要求1所述的多功能菌絲球強化型好氧顆粒污泥,其特征在于,所述多功能菌絲球強化型好氧顆粒污泥滿足以下條件a至q中的至少一者:a.所述多功能菌絲球的形態(tài)包括球形、橢球形、橄欖球形、放射狀球形、不規(guī)則球形中的至少一種;b.所述真菌的鹽度耐受能力,以氯化鈉計為1g/L至100g/L;c.所述真菌的鹽度耐受能力,以電導率計為2mS/cm至170mS/cm;d.步驟2)中,所述培養(yǎng)基為液體培養(yǎng)基;e.步驟2)中,所述培養(yǎng)基含有5g/L至80g/L葡萄糖、0.5g/L至8g/LNH4Cl、0.3g/L至6g/LKH2PO4、0.25g/L至4g/LMgSO4·7H2O、0g/L至80g/LNaCl;f.步驟2)中,所述培養(yǎng)基含有5g/L至80g/L葡萄糖、0.5g/L至8g/LNH4Cl、0.3g/L至6g/LKH2PO4、0.25g/L至4g/LMgSO4·7H2O、0g/L至80g/LNaCl,加水定容至1L;g.步驟2)中,所述培養(yǎng)基經(jīng)過高壓滅菌;h.步驟2)中,真菌孢子的接種量為1×102至1×107個孢子/mL培養(yǎng)基;i.步驟2)中,真菌孢子的接種量為1×102至1×107個孢子/g培養(yǎng)基;j.步驟2)中,所述多功能菌絲球的培養(yǎng)條件為15℃至35℃下培養(yǎng);k.步驟2)中,所述多功能菌絲球的培養(yǎng)條件為60rpm至400rpm下培養(yǎng);l.步驟2)中,所述多功能菌絲球的培養(yǎng)條件為恒溫培養(yǎng)20h至240h;m.步驟3)中,所述多功能菌絲球的接種量為0.1g/L至10g/L;n.步驟3)中,在反應器中接種所述多功能菌絲球和活性污泥;接種所述活性污泥與多功能菌絲球的質(zhì)量比為0至90:1;o.步驟4)中,所述序批式運行的過程包括進水、曝氣、靜置沉降、出水和閑置階段;p.步驟4)中,所述廢水為油氣田壓返液,所述油氣田壓返液的來源包括油田壓返液、天然氣田采出水、頁巖氣壓返液、頁巖氣采出水、致密氣采出水中的至少一種;q.步驟4)中,所述廢水為油氣田壓返液,所述油氣田壓返液中包含聚丙烯酰胺、瓜膠、異丙醇、乙二醇、碳氫化合物、雜環(huán)化合物、苯酚、苯胺、石油及其衍生物中的至少一種;任選地,所述碳氫化合物包含多環(huán)芳烴、烷基苯、脂肪族碳氫化合物及其衍生物中的至少一種。
4.根據(jù)權利要求1-3中任一項所述的多功能菌絲球強化型好氧顆粒污泥,其特征在于,步驟4)中,序批式運行滿足以下條件a至g中的至少一者:a.序批式運行的每個運行周期的總時間為1h至24h;b.序批式運行時反應體系的pH維持在5至9;c.序批式運行時的反應溫度維持在15℃至35℃;d.序批式運行時每周期體積交換率維持在30%至80%;e.在序批式運行的曝氣階段,空氣由底部進入,表觀氣速維持在0.1cm/s至4.5cm/s,溶解氧濃度控制在2mg/L至10mg/L;f.序批式運行時靜置沉降階段的時間范圍是0.1min至30min;g.序批式運行時反應體系的有機負荷范圍為0.3kgCOD/(m3·天)至25kgCOD/(m3·天)。
5.多功能菌絲球強化好氧顆粒污泥處理油氣田壓返液的方法,其特征在于,所述方法包括以下步驟:1)接種真菌菌株,培養(yǎng)成熟后洗滌獲得真菌孢子懸浮液;2)在培養(yǎng)基中接種所述真菌孢子懸浮液,培養(yǎng)并獲得多功能菌絲球;3)在反應器中接種所述多功能菌絲球;4)將廢水引入到反應器中,序批式運行所述反應器處理廢水,培養(yǎng)并獲得多功能菌絲球強化型好氧顆粒污泥,所述廢水為油氣田壓返液;其中所述真菌包括聚多曲霉、極細枝孢霉中的至少一種。
6.根據(jù)權利要求5所述的方法,其特征在于,所述聚多曲霉的名稱為聚多曲霉NXY1(AspergillussydowiiNXY1),保藏編號為CGMCCNo:40215;所述極細枝孢霉的名稱為極細枝孢霉NXY8(CladosporiumtenuissimumNXY8),保藏編號為CGMCCNo:40141。
7.根據(jù)權利要求5所述的方法,其特征在于,所述多功能菌絲球強化型好氧顆粒污泥滿足以下條件a至o中的至少一者:a.所述多功能菌絲球的形態(tài)包括球形、橢球形、橄欖球形、放射狀球形、不規(guī)則球形中的至少一種;b.所述真菌的鹽度耐受能力,以氯化鈉計為1g/L至100g/L;c.所述真菌的鹽度耐受能力,以電導率計為2mS/cm至170mS/cm;d.步驟2)中,所述培養(yǎng)基為液體培養(yǎng)基;e.步驟2)中,所述培養(yǎng)基含有5g/L至80g/L葡萄糖、0.5g/L至8g/LNH4Cl、0.3g/L至6g/LKH2PO4、0.25g/L至4g/LMgSO4·7H2O、0g/L至80g/LNaCl;f.步驟2)中,所述培養(yǎng)基含有5g/L至80g/L葡萄糖、0.5g/L至8g/LNH4Cl、0.3g/L至6g/LKH2PO4、0.25g/L至4g/LMgSO4·7H2O、0g/L至80g/LNaCl,加水定容至1L;g.步驟2)中,所述培養(yǎng)基經(jīng)過高壓滅菌;h.步驟2)中,真菌孢子的接種量為1×102至1×107個孢子/mL培養(yǎng)基;i.步驟2)中,真菌孢子的接種量為1×102至1×107個孢子/g培養(yǎng)基;j.步驟2)中,所述多功能菌絲球的培養(yǎng)條件為15℃至35℃下培養(yǎng);k.步驟2)中,所述多功能菌絲球的培養(yǎng)條件為60rpm至400rpm下培養(yǎng);l.步驟2)中,所述多功能菌絲球的培養(yǎng)條件為恒溫培養(yǎng)20h至240h;m.步驟3)中,所述多功能菌絲球的接種量為0.1g/L至10g/L;n.步驟3)中,在反應器中接種所述多功能菌絲球和活性污泥;接種所述活性污泥與多功能菌絲球的質(zhì)量比為0至90:1;o.步驟4)中,所述序批式運行的過程包括進水、曝氣、靜置沉降、出水和閑置階段。
8.根據(jù)權利要求5所述的方法,其特征在于,步驟4)中,序批式運行滿足以下條件a至g中的至少一者:a.序批式運行的每個運行周期的總時間為1h至24h;b.序批式運行時反應體系的pH維持在5至9;c.序批式運行時的反應溫度維持在15℃至35℃;d.序批式運行時每周期體積交換率維持在30%至80%;e.在序批式運行的曝氣階段,空氣由底部進入,表觀氣速維持在0.1cm/s至4.5cm/s,溶解氧濃度控制在2mg/L至10mg/L;f.序批式運行時靜置沉降階段的時間范圍是0.1min至30min;g.序批式運行時反應體系的有機負荷范圍為0.3kgCOD/(m3·天)至25kgCOD/(m3·天)。
9.根據(jù)權利要求5所述的方法,其特征在于,步驟4)中,所述油氣田壓返液的來源包括油田壓返液、天然氣田采出水、頁巖氣壓返液、頁巖氣采出水、致密氣采出水中的至少一種。
10.根據(jù)權利要求5-9中任一項所述的方法,其特征在于,步驟4)中,所述油氣田壓返液中包含聚丙烯酰胺、瓜膠、異丙醇、乙二醇、碳氫化合物、雜環(huán)化合物、苯酚、苯胺、石油及其衍生物中的至少一種;任選地,所述碳氫化合物包含多環(huán)芳烴、烷基苯、脂肪族碳氫化合物及其衍生物中的至少一種。
發(fā)明內(nèi)容
針對現(xiàn)有技術存在的問題,在第一方面,本發(fā)明的目的在于提供一種多功能菌絲球強化型好氧顆粒污泥。在第二方面,本發(fā)明的目的在于提供一種多功能菌絲球強化好氧顆粒污泥處理油氣田壓返液的方法。本發(fā)明采用多功能菌絲球接種策略,不僅具備加速培養(yǎng)好氧顆粒污泥的能力,該多功能菌絲球還可以耐受較寬范圍鹽度并且降解油氣田壓返液中有機物,可以實現(xiàn)體系啟動期污染物的高效去除,并且可以在高有機負荷下啟動。
本發(fā)明采用以下技術方案:
在第一方面,本申請?zhí)峁┝艘环N多功能菌絲球以及多功能菌絲球強化型好氧顆粒污泥,所述多功能菌絲球通過包括或由以下步驟1)和2)的方法制備得到,所述多功能菌絲球強化型好氧顆粒污泥通過包括或由以下步驟1)至4)的方法制備得到:
1)接種真菌菌株,可選地,例如將真菌菌株于固體培養(yǎng)基上,例如可以采用在馬鈴薯葡萄糖瓊脂(PDA)斜面劃線接種(多功能)真菌菌株,培養(yǎng)成熟后洗滌獲得真菌孢子懸浮液;任選地,洗滌的方式可以采用水洗滌,優(yōu)選地,所述水為去離子水、蒸餾水、雙蒸水、超純水、無菌水中的至少一種;
作為示例而并非限制,將保存(多功能)真菌菌株的甘油管從-80℃冰箱中取出,采用接種環(huán)在無菌馬鈴薯葡萄糖瓊脂(PDA)培養(yǎng)基斜面上劃線,并將劃好線的斜面置于約30℃的培養(yǎng)箱中培養(yǎng)約7天。在超凈臺中將斜面上的孢子洗到無菌生理鹽水中制得孢子懸浮液,并采用血球計數(shù)法在顯微鏡下數(shù)出每毫升孢子懸浮液中的孢子數(shù)量。
2)在培養(yǎng)基中接種所述真菌孢子懸浮液,培養(yǎng)并獲得多功能菌絲球;
作為示例而并非限制,將真菌孢子懸浮液接種到裝有無菌培養(yǎng)基的搖瓶中,接種量為例如103個孢子/mL培養(yǎng)液。其中任選地無菌培養(yǎng)基由10g/L無水葡萄糖、1g/LNH4Cl、0.72g/LKH2PO4、0.5g/LMgSO4·7H2O和30g/LNaCl組成,加去離子水定容至1L,再經(jīng)滅菌后制得。將接種孢子懸浮液后的搖瓶置于搖床中,例如可以在25℃、200rpm下恒溫培養(yǎng)144h,得到菌絲球。
3)在反應器中接種所述多功能菌絲球;例如,所述反應器為廢水處理反應器;
4)將廢水引入到反應器中,序批式運行所述反應器處理廢水,培養(yǎng)并獲得所述多功能菌絲球強化型好氧顆粒污泥;
其中所述真菌包括聚多曲霉、極細枝孢霉中的至少一種;所述真菌由聚多曲霉、極細枝孢霉中的至少一種組成。例如,所述真菌為聚多曲霉;可替代地,所述真菌為極細枝孢霉。
在本文中,(多功能)真菌具備降解油氣田壓返液中有機物的特性,同時具有可成球的特性及寬范圍的鹽度耐受性。
不希望受到理論的束縛,在一些可行的實施方案中,所述聚多曲霉的名稱為聚多曲霉NXY1(AspergillussydowiiNXY1),已于2022年06月17日保藏于中國微生物菌株保藏管理委員會普通微生物中心(CGMCC),保藏編號為CGMCCNo:40215。
不希望受到理論的束縛,在一些可行的實施方案中,所述極細枝孢霉的名稱為極細枝孢霉NXY8(CladosporiumtenuissimumNXY8),已于2022年03月04日保藏于中國微生物菌株保藏管理委員會普通微生物中心(CGMCC),保藏編號為CGMCCNo:40141。
結合第一方面,在一些可行的實施方案中,所述多功能菌絲球的形態(tài)包括但不限于球形、橢球形、橄欖球形、放射狀球形、不規(guī)則球形中的至少一種。
結合第一方面,在一些可行的實施方案中,所述真菌的鹽度耐受能力,以氯化鈉計為1g/L至100g/L,例如1、2、3、4、5、6、7、8、9、10、11、12、13、14、15、16、17、18、19、20、21、22、23、24、25、26、27、28、29、30、31、32、33、34、35、36、37、38、39、40、41、42、43、44、45、46、47、48、49、50、51、52、53、54、55、56、57、58、59、60、61、62、63、64、65、66、67、68、69、70、71、72、73、74、75、76、77、78、79、80、81、82、83、84、85、86、87、88、89、90、91、92、93、94、95、96、97、說 明 書2/15頁6CN115710049A698、99、100g/L,等等,但并不僅限于所列舉的數(shù)值,該數(shù)值范圍內(nèi)其他未列舉的數(shù)值或范圍同樣適用。
結合第一方面,在一些可替代的實施方案中,所述真菌可耐受的鹽度范圍為高達10%,例如高達9%、高達8%、高達7%、高達6%,例如5%、4%、3%、2%、1%,等等,但并不僅限于所列舉的數(shù)值,該數(shù)值范圍內(nèi)其他未列舉的數(shù)值或范圍同樣適用。
結合第一方面,在一些可行的實施方案中,所述真菌的鹽度耐受能力,以電導率(例如,使用電導率儀在25℃下測定)計為2mS/cm至170mS/cm,例如2、3、4、5、6、7、8、9、10、11、12、13、14、15、16、17、18、19、20、21、22、23、24、25、26、27、28、29、30、31、32、33、34、35、36、37、38、39、40、41、42、43、44、45、46、47、48、49、50、51、52、53、54、55、56、57、58、59、60、61、62、63、64、65、66、67、68、69、70、71、72、73、74、75、76、77、78、79、80、81、82、83、84、85、86、87、88、89、90、91、92、93、94、95、96、97、98、99、100、110、120、130、140、150、160、170mS/cm,等等,但并不僅限于所列舉的數(shù)值,該數(shù)值范圍內(nèi)其他未列舉的數(shù)值或范圍同樣適用。
結合第一方面,在一些可行的實施方案中,步驟2)中,所述培養(yǎng)基為液體培養(yǎng)基。
結合第一方面,在一些可行的實施方案中,步驟2)中,所述培養(yǎng)基含有或由以下項組成:5g/L至80g/L葡萄糖、0.5g/L至8g/LNH4Cl、0.3g/L至6g/LKH2PO4、0.25g/L至4g/LMgSO4·7H2O、0g/L至80g/LNaCl;任選地,所述葡萄糖為無水葡萄糖。
結合第一方面,在一些可行的實施方案中,步驟2)中,所述培養(yǎng)基含有或由以下項組成:5g/L至80g/L葡萄糖、0.5g/L至8g/LNH4Cl、0.3g/L至6g/LKH2PO4、0.25g/L至4g/LMgSO4·7H2O、0g/L至80g/LNaCl,加水定容至1L;任選地,所述葡萄糖為無水葡萄糖。
結合第一方面,在一些可行的實施方案中,步驟2)中,所述培養(yǎng)基經(jīng)過高壓滅菌后制得。
結合第一方面,在一些可行的實施方案中,步驟2)中,真菌孢子的接種量為1×102至1×107個孢子/mL培養(yǎng)基,例如約1×102、1×103、1×104、1×105、1×106、1×107個孢子/mL培養(yǎng)基,等等,但并不僅限于所列舉的數(shù)值,該數(shù)值范圍內(nèi)其他未列舉的數(shù)值或范圍同樣適用。
結合第一方面,在一些可行的實施方案中,步驟2)中,真菌孢子的接種量為1×102至1×107個孢子/g培養(yǎng)基,例如約1×102、1×103、1×104、1×105、1×106、1×107個孢子/g培養(yǎng)基,等等,但并不僅限于所列舉的數(shù)值,該數(shù)值范圍內(nèi)其他未列舉的數(shù)值或范圍同樣適用。
結合第一方面,在一些可行的實施方案中,步驟2)中,所述多功能菌絲球的培養(yǎng)條件為15℃至35℃下培養(yǎng),例如15、16、17、18、19、20、21、22、23、24、25、26、27、28、29、30、31、32、33、34、35℃,等等,但并不僅限于所列舉的數(shù)值,該數(shù)值范圍內(nèi)其他未列舉的數(shù)值或范圍同樣適用。
結合第一方面,在一些可行的實施方案中,步驟2)中,所述多功能菌絲球的培養(yǎng)條件為60rpm至400rpm下培養(yǎng),例如60、70、80、90、100、110、120、130、140、150、160、170、180、190、200、210、220、230、240、250、260、270、280、290、300、310、320、330、340、350、360、370、380、390、400rpm,等等,但并不僅限于所列舉的數(shù)值,該數(shù)值范圍內(nèi)其他未列舉的數(shù)值或范圍同樣適用。
結合第一方面,在一些可行的實施方案中,步驟2)中,所述多功能菌絲球的培養(yǎng)條說 明 書3/15頁7CN115710049A7件為恒溫培養(yǎng)20h至240h,例如20、30、40、50、60、70、80、90、100、110、120、130、140、150、160、170、180、190、200、210、220、230、240h,等等,但并不僅限于所列舉的數(shù)值,該數(shù)值范圍內(nèi)其他未列舉的數(shù)值或范圍同樣適用。
結合第一方面,在一些可行的實施方案中,步驟3)中,所述多功能菌絲球的接種量為0.1g/L至10g/L,例如,0.1、0.2、0.3、0.4、0.5、0.6、0.7、0.8、0.9、1、2、3、4、5、6、7、8、9、10g/L,等等,但并不僅限于所列舉的數(shù)值,該數(shù)值范圍內(nèi)其他未列舉的數(shù)值或范圍同樣適用。
結合第一方面,在一些可行的實施方案中,步驟3)中,在反應器中接種所述多功能菌絲球和活性污泥;接種所述活性污泥與多功能菌絲球的質(zhì)量比為0至90:1,例如1:1,2:1,3:1,4:1,5:1,6:1,7:1,8:1,9:1,10:1,20:1,30:1,40:1,50:1,60:1,70:1,80:1,90:1,等等,但并不僅限于所列舉的數(shù)值,該數(shù)值范圍內(nèi)其他未列舉的數(shù)值或范圍同樣適用。
結合第一方面,在一些可行的實施方案中,步驟4)中,所述序批式運行的過程包括進水、曝氣、靜置沉降、出水和閑置階段。
結合第一方面,在一些可行的實施方案中,步驟4)中,序批式運行的每個運行周期的總時間為1h至24h,例如1、2、3、4、5、6、7、8、9、10、11、12、13、14、15、16、17、18、19、20、21、22、23、24h,等等,但并不僅限于所列舉的數(shù)值,該數(shù)值范圍內(nèi)其他未列舉的數(shù)值或范圍同樣適用。
結合第一方面,在一些可行的實施方案中,步驟4)中,序批式運行時反應體系的pH維持在5至9,例如5、6、7、8、9,等等,但并不僅限于所列舉的數(shù)值,該數(shù)值范圍內(nèi)其他未列舉的數(shù)值或范圍同樣適用。
結合第一方面,在一些可行的實施方案中,步驟4)中,序批式運行時的反應溫度維持在15℃至35℃,例如15、16、17、18、19、20、21、22、23、24、25、26、27、28、29、30、31、32、33、34、35℃,等等,但并不僅限于所列舉的數(shù)值,該數(shù)值范圍內(nèi)其他未列舉的數(shù)值或范圍同樣適用。
結合第一方面,在一些可行的實施方案中,步驟4)中,序批式運行時每周期體積交換率維持在30%至80%,例如30%、40%、50%、60%、70%、80%,等等,但并不僅限于所列舉的數(shù)值,該數(shù)值范圍內(nèi)其他未列舉的數(shù)值或范圍同樣適用。
結合第一方面,在一些可行的實施方案中,步驟4)中,在序批式運行的曝氣階段,空氣由底部進入,表觀氣速(空氣流量與反應器內(nèi)截面積的比值)維持在0.1cm/s至4.5cm/s,例如0.5、0.6、0.7、0.8、0.9、1、2、3、4、4.5cm/s;溶解氧濃度控制在2mg/L至10mg/L,例如2、3、4、5、6、7、8、9、10mg/L,等等,但并不僅限于所列舉的數(shù)值,該數(shù)值范圍內(nèi)其他未列舉的數(shù)值或范圍同樣適用。
結合第一方面,在一些可行的實施方案中,步驟4)中,序批式運行時靜置沉降階段的時間范圍是0.1min至30min,例如0.1、0.5、1、2、3、4、5、6、7、8、9、10、11、12、13、14、15、16、17、18、19、20、21、22、23、24、25、26、27、28、29、30min,等等,但并不僅限于所列舉的數(shù)值,該數(shù)值范圍內(nèi)其他未列舉的數(shù)值或范圍同樣適用。
結合第一方面,在一些可行的實施方案中,步驟4)中,序批式運行時反應體系的有機負荷范圍為0.3kgCOD/(m3·天)至25kgCOD/(m3·天),例如0.3、0.5、0.8、1.2、1.5、2、3、4、5、6、7、8、9、10、11、12、13、14、15、16、17、18、19、20、21、22、23、24、25kgCOD/(m3·天),等等,但并不僅限于所列舉的數(shù)值,該數(shù)值范圍內(nèi)其他未列舉的數(shù)值或范圍同樣適用。
結合第一方面,在一些可行的實施方案中,所述廢水為油氣田壓返液,所述油氣田壓返液的來源包括或由以下項組成:油田壓返液、天然氣田采出水、頁巖氣壓返液、頁巖氣采出水、致密氣采出水中的至少一種。
結合第一方面,在一些可行的實施方案中,所述廢水為油氣田壓返液,所述油氣田壓返液中包含或由以下項組成:聚丙烯酰胺、瓜膠、異丙醇、乙二醇、碳氫化合物、雜環(huán)化合物、苯酚、苯胺、石油及其衍生物中的至少一種;任選地,所述碳氫化合物包含多環(huán)芳烴、烷基苯、脂肪族碳氫化合物及其衍生物中的至少一種。
在第二方面,本申請?zhí)峁┝艘环N多功能菌絲球強化好氧顆粒污泥處理油氣田壓返液的方法,包括以下步驟:
1)接種真菌菌株,可選地,例如將真菌菌株于固體培養(yǎng)基上,例如可以采用在馬鈴薯葡萄糖瓊脂(PDA)斜面劃線接種(多功能)真菌菌株,培養(yǎng)成熟后洗滌獲得真菌孢子懸浮液;任選地,洗滌的方式可以采用水洗滌,優(yōu)選地,所述水為去離子水、蒸餾水、雙蒸水、超純水、無菌水中的至少一種;
作為示例而并非限制,將保存(多功能)真菌菌株的甘油管從-80℃冰箱中取出,采用接種環(huán)在無菌馬鈴薯葡萄糖瓊脂(PDA)培養(yǎng)基斜面上劃線,并將劃好線的斜面置于約30℃的培養(yǎng)箱中培養(yǎng)約7天。在超凈臺中將斜面上的孢子洗到無菌生理鹽水中制得孢子懸浮液,并采用血球計數(shù)法在顯微鏡下數(shù)出每毫升孢子懸浮液中的孢子數(shù)量。
2)在培養(yǎng)基中接種所述真菌孢子懸浮液,培養(yǎng)并獲得多功能菌絲球;
3)在反應器中接種所述多功能菌絲球;例如,所述反應器為廢水處理反應器;
4)將廢水引入到反應器中,序批式運行所述反應器培養(yǎng)處理廢水并獲得多功能菌絲球強化型好氧顆粒污泥,所述廢水為油氣田壓返液,通過序批式運行反應器培養(yǎng)的好氧顆粒污泥同時處理油氣田壓返液;
其中所述真菌包括聚多曲霉、極細枝孢霉中的至少一種;所述真菌由聚多曲霉、極細枝孢霉中的至少一種組成。例如,所述真菌為聚多曲霉;可替代地,所述真菌為極細枝孢霉。
結合第二方面,在一些可行的實施方案中,所述聚多曲霉的名稱為聚多曲霉NXY1(AspergillussydowiiNXY1),保藏編號為CGMCCNo:40215;和/或,所述極細枝孢霉的名稱為極細枝孢霉NXY8(CladosporiumtenuissimumNXY8),保藏編號為CGMCCNo:40141。
結合第二方面,在一些可行的實施方案中,所述多功能菌絲球的形態(tài)包括球形、橢球形、橄欖球形、放射狀球形、不規(guī)則球形中的至少一種。
結合第二方面,在一些可行的實施方案中,所述真菌的鹽度耐受能力,以氯化鈉計為1g/L至100g/L,例如1、2、3、4、5、6、7、8、9、10、11、12、13、14、15、16、17、18、19、20、21、22、23、24、25、26、27、28、29、30、31、32、33、34、35、36、37、38、39、40、41、42、43、44、45、46、47、48、49、50、51、52、53、54、55、56、57、58、59、60、61、62、63、64、65、66、67、68、69、70、71、72、73、74、75、76、77、78、79、80、81、82、83、84、85、86、87、88、89、90、91、92、93、94、95、96、97、98、99、100g/L,等等,但并不僅限于所列舉的數(shù)值,該數(shù)值范圍內(nèi)其他未列舉的數(shù)值或范圍同樣適用。
結合第二方面,在一些可替代的實施方案中,所述真菌可耐受的鹽度范圍為10%,例如高達9%、高達8%、高達7%、高達6%,例如5%、4%、3%、2%、1%,等等,但并不僅限于所列舉的數(shù)值,該數(shù)值范圍內(nèi)其他未列舉的數(shù)值或范圍同樣適用。
結合第二方面,在一些可行的實施方案中,所述真菌的鹽度耐受能力,以電導率(例如,使用電導率儀在25℃下測定)計為2mS/cm至170mS/cm,例如2、3、4、5、6、7、8、9、10、11、12、13、14、15、16、17、18、19、20、21、22、23、24、25、26、27、28、29、30、31、32、33、34、35、36、37、38、39、40、41、42、43、44、45、46、47、48、49、50、51、52、53、54、55、56、57、58、59、60、61、62、63、64、65、66、67、68、69、70、71、72、73、74、75、76、77、78、79、80、81、82、83、84、85、86、87、88、89、90、91、92、93、94、95、96、97、98、99、100、110、120、130、140、150、160、170mS/cm,等等,但并不僅限于所列舉的數(shù)值,該數(shù)值范圍內(nèi)其他未列舉的數(shù)值或范圍同樣適用。
結合第二方面,在一些可行的實施方案中,步驟2)中,所述培養(yǎng)基為液體培養(yǎng)基。
結合第二方面,在一些可行的實施方案中,步驟2)中,所述培養(yǎng)基含有或由以下項組成:5g/L至80g/L葡萄糖、0.5g/L至8g/LNH4Cl、0.3g/L至6g/LKH2PO4、0.25g/L至4g/LMgSO4·7H2O、0g/L至80g/LNaCl;任選地,所述葡萄糖為無水葡萄糖。
結合第二方面,在一些可行的實施方案中,步驟2)中,所述培養(yǎng)基含有或由以下項組成:5g/L至80g/L葡萄糖、0.5g/L至8g/LNH4Cl、0.3g/L至6g/LKH2PO4、0.25g/L至4g/LMgSO4·7H2O、0g/L至80g/LNaCl,加水定容至1L;任選地,所述葡萄糖為無水葡萄糖。
結合第二方面,在一些可行的實施方案中,步驟2)中,所述培養(yǎng)基經(jīng)過高壓滅菌后制得。
結合第二方面,在一些可行的實施方案中,步驟2)中,真菌孢子的接種量為1×102至1×107個孢子/mL培養(yǎng)基,例如約1×102、1×103、1×104、1×105、1×106、1×107個孢子/mL培養(yǎng)基,等等,但并不僅限于所列舉的數(shù)值,該數(shù)值范圍內(nèi)其他未列舉的數(shù)值或范圍同樣適用。
結合第二方面,在一些可行的實施方案中,步驟2)中,真菌孢子的接種量為1×102至1×107個孢子/g培養(yǎng)基,例如約1×102、1×103、1×104、1×105、1×106、1×107個孢子/g培養(yǎng)基,等等,但并不僅限于所列舉的數(shù)值,該數(shù)值范圍內(nèi)其他未列舉的數(shù)值或范圍同樣適用。
結合第二方面,在一些可行的實施方案中,步驟2)中,所述多功能菌絲球的培養(yǎng)條件為15℃至35℃下培養(yǎng),例如15、16、17、18、19、20、21、22、23、24、25、26、27、28、29、30、31、32、33、34、35℃,等等,但并不僅限于所列舉的數(shù)值,該數(shù)值范圍內(nèi)其他未列舉的數(shù)值或范圍同樣適用。
結合第二方面,在一些可行的實施方案中,步驟2)中,所述多功能菌絲球的培養(yǎng)條件為60rpm至400rpm下培養(yǎng),例如60、70、80、90、100、110、120、130、140、150、160、170、180、190、200、210、220、230、240、250、260、270、280、290、300、310、320、330、340、350、360、370、380、390、400rpm,等等,但并不僅限于所列舉的數(shù)值,該數(shù)值范圍內(nèi)其他未列舉的數(shù)值或范圍同樣適用。
結合第二方面,在一些可行的實施方案中,步驟2)中,所述多功能菌絲球的培養(yǎng)條件為恒溫培養(yǎng)20h至240h,例如20、30、40、50、60、70、80、90、100、110、120、130、140、150、160、170、180、190、200、210、220、230、240h,等等,但并不僅限于所列舉的數(shù)值,該數(shù)值范圍內(nèi)其他未列舉的數(shù)值或范圍同樣適用。
結合第二方面,在一些可行的實施方案中,步驟3)中,所述多功能菌絲球的接種量為0.1g/L至10g/L,例如,0.1、0.2、0.3、0.4、0.5、0.6、0.7、0.8、0.9、1、2、3、4、5、6、7、8、9、10g/L,等等,但并不僅限于所列舉的數(shù)值,該數(shù)值范圍內(nèi)其他未列舉的數(shù)值或范圍同樣適用。
結合第二方面,在一些可行的實施方案中,步驟3)中,在反應器中接種所述多功能菌絲球和活性污泥;接種所述活性污泥與多功能菌絲球的質(zhì)量比為0至90:1,例如1:1,2:1,3:1,4:1,5:1,6:1,7:1,8:1,9:1,10:1,20:1,30:1,40:1,50:1,60:1,70:1,80:1,90:1,等等,但并不僅限于所列舉的數(shù)值,該數(shù)值范圍內(nèi)其他未列舉的數(shù)值或范圍同樣適用。
結合第二方面,在一些可行的實施方案中,步驟4)中,所述序批式運行的過程包括進水、曝氣、靜置沉降、出水和閑置階段。
結合第二方面,在一些可行的實施方案中,步驟4)中,序批式運行的每個運行周期的總時間為1h至24h,例如1、2、3、4、5、6、7、8、9、10、11、12、13、14、15、16、17、18、19、20、21、22、23、24h,等等,但并不僅限于所列舉的數(shù)值,該數(shù)值范圍內(nèi)其他未列舉的數(shù)值或范圍同樣適用。
結合第二方面,在一些可行的實施方案中,步驟4)中,序批式運行時反應體系的pH維持在5至9,例如5、6、7、8、9,等等,但并不僅限于所列舉的數(shù)值,該數(shù)值范圍內(nèi)其他未列舉的數(shù)值或范圍同樣適用。
結合第二方面,在一些可行的實施方案中,步驟4)中,序批式運行時的反應溫度維持在15℃至35℃,例如15、16、17、18、19、20、21、22、23、24、25、26、27、28、29、30、31、32、33、34、35℃,等等,但并不僅限于所列舉的數(shù)值,該數(shù)值范圍內(nèi)其他未列舉的數(shù)值或范圍同樣適用。
結合第二方面,在一些可行的實施方案中,步驟4)中,序批式運行時每周期體積交換率維持在30%至80%,例如30%、40%、50%、60%、70%、80%,等等,但并不僅限于所列舉的數(shù)值,該數(shù)值范圍內(nèi)其他未列舉的數(shù)值或范圍同樣適用。
結合第二方面,在一些可行的實施方案中,步驟4)中,在序批式運行的曝氣階段,空氣由底部進入,表觀氣速(空氣流量與反應器內(nèi)截面積的比值)維持在0.1cm/s至4.5cm/s,例如0.5、0.6、0.7、0.8、0.9、1、2、3、4、4.5cm/s;溶解氧濃度控制在2mg/L至10mg/L,例如2、3、4、5、6、7、8、9、10mg/L,等等,但并不僅限于所列舉的數(shù)值,該數(shù)值范圍內(nèi)其他未列舉的數(shù)值或范圍同樣適用。
結合第二方面,在一些可行的實施方案中,步驟4)中,序批式運行時靜置沉降階段的時間范圍是0.1min至30min,例如0.1、0.5、1、2、3、4、5、6、7、8、9、10、11、12、13、14、15、16、17、18、19、20、21、22、23、24、25、26、27、28、29、30min,等等,但并不僅限于所列舉的數(shù)值,該數(shù)值范圍內(nèi)其他未列舉的數(shù)值或范圍同樣適用。
結合第二方面,在一些可行的實施方案中,步驟4)中,序批式運行時反應體系的有機負荷范圍為0.3kgCOD/(m3·天)至25kgCOD/(m3·天),例如0.3、0.5、0.8、1.2、1.5、2、3、4、5、6、7、8、9、10、11、12、13、14、15、16、17、18、19、20、21、22、23、24、25kgCOD/(m3·天),等等,但并不僅限于所列舉的數(shù)值,該數(shù)值范圍內(nèi)其他未列舉的數(shù)值或范圍同樣適用。
結合第二方面,在一些可行的實施方案中,所述廢水為油氣田壓返液,所述油氣田壓返液的來源包括或由以下項組成:油田壓返液、天然氣田采出水、頁巖氣壓返液、頁巖氣采出水、致密氣采出水中的至少一種。
結合第二方面,在一些可行的實施方案中,所述廢水為油氣田壓返液,所述油氣田壓返液中包含或由以下項組成:聚丙烯酰胺、瓜膠、異丙醇、乙二醇、碳氫化合物、雜環(huán)化合物、苯酚、苯胺、石油及其衍生物中的至少一種;任選地,所述碳氫化合物包含多環(huán)芳烴、烷基苯、脂肪族碳氫化合物及其衍生物中的至少一種。
如本文中所使用的術語“壓返液”可以與“壓裂返排液”可互換地使用。
如本文中所使用的術語“頁巖氣采出水”中包含來自壓裂液的大量化學添加組分,例如凝膠劑、減阻劑、交聯(lián)劑、殺菌劑和表面活性劑等,還包含來自地層的金屬離子和烷烴、芳香烴等有機物。
如本文中所使用的術語“有機負荷”是指單位體積廢水處理反應器在單位時間內(nèi)接納的有機污染物量,一般不包括反應器回流中的有機物(采用回流系統(tǒng)時)。有機物可以用COD表示,因此又稱COD負荷,單位為kg/(m3·天)。在污水處理領域,負荷表征污水處理設施可以受納污水的能力,換言之,有機負荷是表示污水處理設施處理能力的指標。
如本文中所使用的術語“好氧顆粒污泥(aerobicgranularsludge,AGS)”是指污泥中微生物在好氧環(huán)境下自凝聚形成的結構致密的生物聚集體。與普通活性污泥相比,好氧顆粒污泥具有不易發(fā)生污泥膨脹、抗沖擊能力強、能承受高有機負荷,集不同性質(zhì)的微生物(好氧、兼氧和厭氧微生物)于一體等特點。
如本文中所使用的術語“菌絲球”是指由絲狀真菌自纏繞形成的球體,它具有大量互相纏繞的菌絲,因此即使不添加起絮凝作用的化學試劑也可以通過細胞間的捕捉作用以及表面電荷的靜電吸附作用聚集環(huán)境中的顆粒物質(zhì)和功能菌群。菌絲球具有比表面積大、吸附性能優(yōu)越、沉降速度快、利于固液分離、生物相容性高、不產(chǎn)生二次污染等特點。
菌絲球粒徑測定方法,隨機取30顆菌絲球,拍照后使用圖像處理軟件(ImageJ.JS,v0.5.5)測量菌絲球直徑,取平均值為菌絲球的平均粒徑。
如本文中所使用的術語“序批式反應器(SequencingBatchReactor,SBR)”是指按時間順序間歇操作運行的反應器,其特點是在空間上完全混合,時間上交替進行,整個處理過程(包括除磷脫氮過程)在同一反應器中進行。
本申請中的好氧顆粒污泥展現(xiàn)出了替代傳統(tǒng)活性污泥技術的巨大潛力:(1)顆粒污泥具備優(yōu)異的沉降性能,可以省去占地面積較大的二沉池和耗能巨大的回流設施;(2)好氧顆粒污泥結構致密,因而該技術具備污泥含量高、污泥持留能力強、抗逆(例如鹽度、有毒物質(zhì)、水質(zhì)波動沖擊等)性能強等優(yōu)勢;(3)好氧顆粒污泥具備層次結構,內(nèi)層核心為厭氧/缺氧區(qū),外層為好氧區(qū),這賦予不同微生物適宜的生態(tài)位,使得生物氧化、硝化、反硝化、聚磷等多個生物反應可以在同一顆粒中進行。
本申請中的菌絲球具有沉降速度快、固液分離容易、生物活性高、對污染物吸附能力強、能分泌多種酶等優(yōu)點。將菌絲球投加到活性污泥中,可以作為核心載體,為微生物提供吸附生長的空間,促進微生物的聚集,從而加速顆粒污泥的形成。
本申請中的溫度參數(shù),如無特別限定,既允許為恒溫處理,也允許在一定溫度區(qū)間內(nèi)進行處理。所述的恒溫處理允許溫度在儀器控制的精度范圍內(nèi)進行波動。
相比于現(xiàn)有技術,本發(fā)明的有益效果:
(1)相比于現(xiàn)有技術,本發(fā)明選用的菌絲球屬于多功能菌絲球,具備降解頁巖氣壓返液中有機物的能力,可以釋放胞外酶降解或自身代謝頁巖氣壓返液中的有機物,提升反應體系的處理負荷。同時,菌絲結構可以為其他微生物提供骨架,提升其他功能微生物的停留時間,避免隨出水排出。此外,菌絲球結構可以更好地提升污泥的沉降性能,減少二沉池的構筑,并且顯著加速污泥造粒,形成好氧顆粒污泥后可以以更為優(yōu)異的性能同步脫氮除碳;
(2)相比于現(xiàn)有技術,本發(fā)明對初始活性污泥的性狀要求低,避免了各地接種污泥性狀不一帶來的困擾,提高了工業(yè)應用的可控性;
(3)相比于現(xiàn)有技術,本發(fā)明選用的菌絲球屬于多功能菌絲球,在反應器啟動前期直接投加具有污染物去除能力的多功能菌絲球,避免了反應器啟動前期因活性污泥不適應油氣田壓返液而導致有機物及氨氮去除率低的問題,保證了出水質(zhì)量;
(4)相比于現(xiàn)有技術,本發(fā)明可以綠色、經(jīng)濟地實現(xiàn)油氣田壓返液污染物的高效去除。
(發(fā)明人:韓昫身;金艷;于建國)






